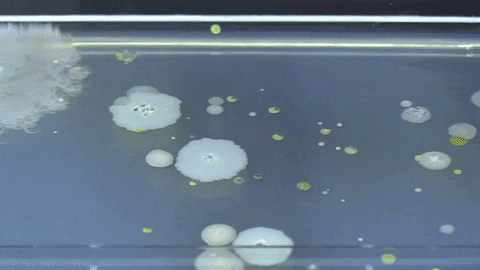

Leading microbiologists challenged us to achieve flawless colony isolation.
We delivered the PIXL colony picker.
Perform high-throughput screening of microbial colonies with unprecedented speed and accuracy.
99% transfer efficiency
With agar surface detection on every pick, PIXL will never miss a colony, damage plates or splash cells all over the place. Read our report here.
Train everyone
90% of the functionality can be learned in as little as 10 minutes. Long gone are the days of needing specialist technicians.
Unique picking technology
33,000 sterile, disposable tips in a single, low-cost PickupLine. That’s <2 cents per pick, cheaper than a pipette tip.
“PIXL for us represented a transformative tool that would really simplify our workflow. It allowed us to go directly from agar plate to agar plate at very high density.”

Dr Kevin Roy
Stanford Genome Technology Center
“PIXL has unlocked new capabilities that were previously unattainable…we can now perform high-throughput screening of microbial colonies with unprecedented speed and accuracy.”

Professor Matthew Chang | Director of the Singapore Consortium for Synthetic Biology (SINERGY) and SynCTI biofoundry.
“PIXL is a powerful tool to pick colonies and rearrange them in different sources. It is quick, efficient, and has a low risk of contamination.”

Professor James Chong | Head of Department of Biology, University of York
1700+ happy microbiologists and counting.
PIXL applications
Descriptions, photos, and videos are great, but nothing beats a live demonstration of PIXL.
Product experts will lead you through the demo and will be able to answer any questions on topics like colony recognition, colony selection, and picking.
Have a particular workflow you’d like to see demonstrated? Please mention it in the ‘What would you like to see?’ section of the form, and we’ll do our best to have it ready for your demo. If we can’t, we’ll find a suitable substitute.













